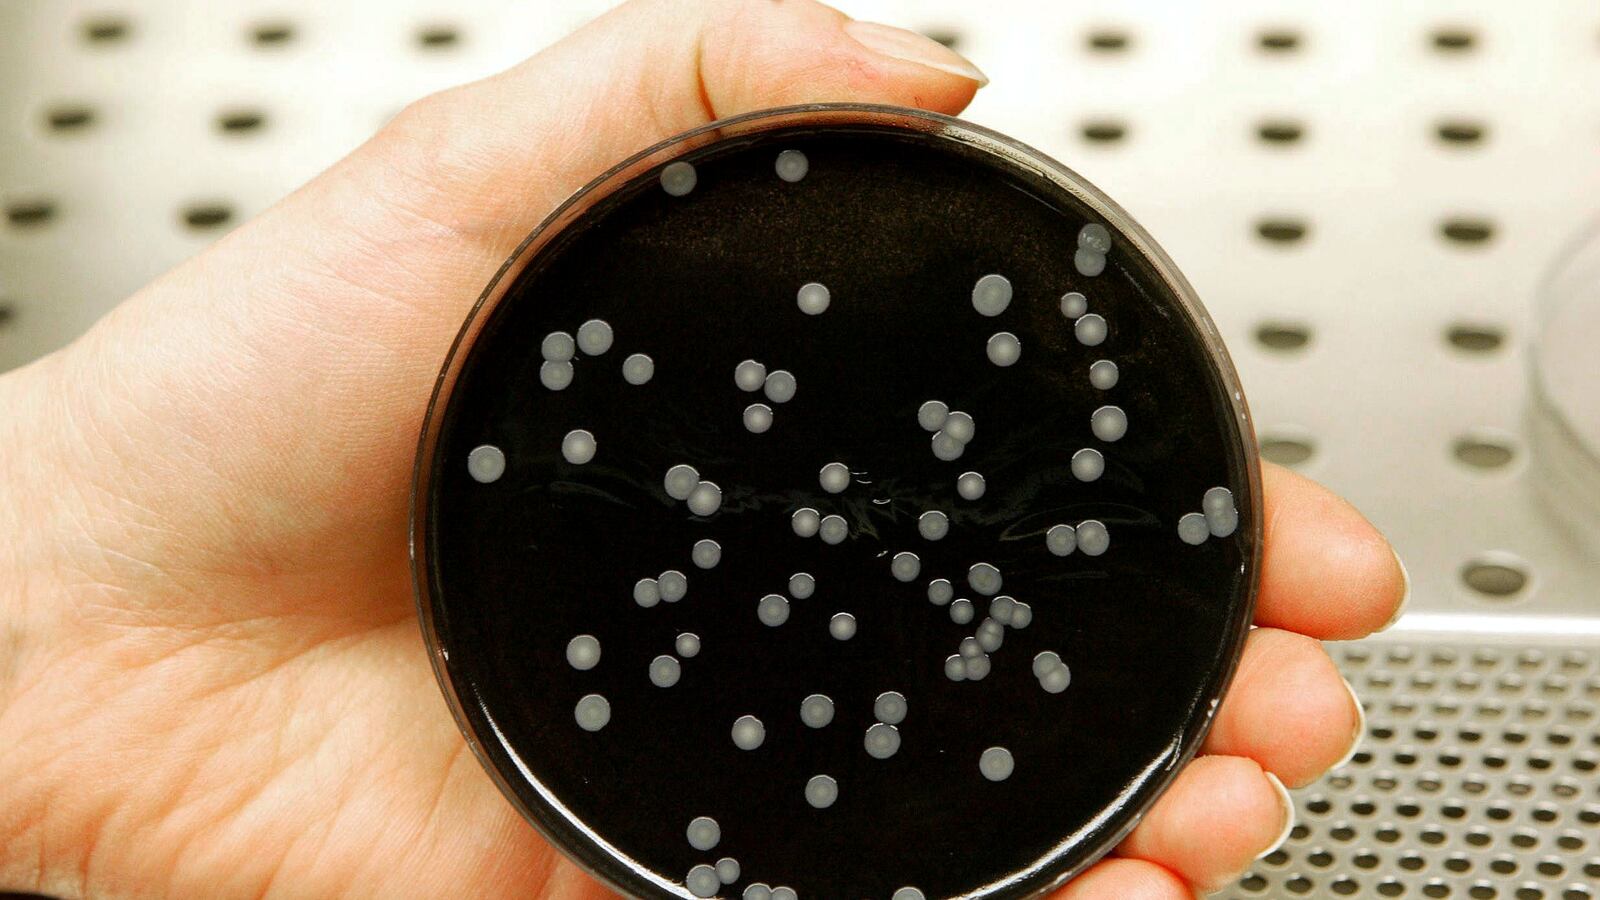
RTXMDL1_njq58c

An Atlanta hotel has halted operations after three of its guests tested positive for Legionnaires’ disease. About 450 individuals are being relocated from the Sheraton Atlanta, which is located in the city’s downtown area, and public health officials are conducting investigations with guests to determine other potential victims. The rare and sometimes deadly form of pneumonia is typically contracted by breathing in infected air or swallowing water with bacteria, The Atlanta Journal-Constitution reports. In Georgia, it is required by law to report cases of the disease, which typically kills about one in 10 people who contract it. While public health officials have not yet confirmed the disease was contracted by the guests during their stay, the hotel is working with experts to try and determine the root of the cause. “The health and safety of our guests is our greatest priority,” general manager Ken Peduzzi said in a statement. “We are working closely with public health officials and outside experts to conduct testing to determine if Legionella is present at the hotel.”
Read it at Atlanta Journal-Constitution